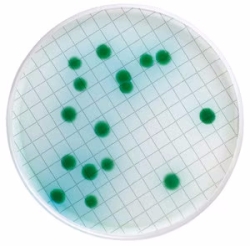
7.628 679
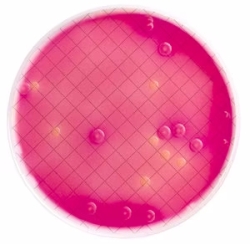
7.628 680
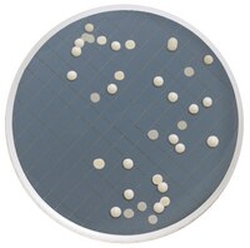
6.273 409
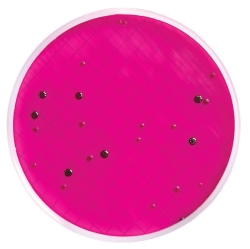
7.644 322

Kulturmedienkassetten Milliflex® / Millipore
Vorgefüllte Kulturmedienkassetten zur Verwendung mit Milliflex® Filtereinheiten.
Artikel wurde dem Warenkorb hinzugefügt.
Kulturmedienkassetten Milliflex®
BeschreibungMenge
pro VE
Preis/Eh.EUR

pro VE
478,40€
569,30€
inkl. Mwst. In denWarenkorb
Bei Artikel 6.079 837 bezieht sich der Preis von 478,40
€
auf die Verpackungseinheit 120.Der rechnerische Preis pro Stück ist 3,99
€
.
pro VE
426,40€
507,42€
inkl. Mwst. In denWarenkorb
Bei Artikel 7.628 679 bezieht sich der Preis von 426,40
€
auf die Verpackungseinheit 48.Der rechnerische Preis pro Stück ist 8,88
€
.
pro VE
208,00€
247,52€
inkl. Mwst. In denWarenkorb
Bei Artikel 7.628 680 bezieht sich der Preis von 208,00
€
auf die Verpackungseinheit 24.Der rechnerische Preis pro Stück ist 8,67
€
.
pro VE
302,00€
359,38€
inkl. Mwst. In denWarenkorb
Bei Artikel 6.256 389 bezieht sich der Preis von 302,00
€
auf die Verpackungseinheit 48.Der rechnerische Preis pro Stück ist 6,29
€
.
pro VE
392,60€
467,19€
inkl. Mwst. In denWarenkorb
Bei Artikel 6.273 409 bezieht sich der Preis von 392,60
€
auf die Verpackungseinheit 48.Der rechnerische Preis pro Stück ist 8,18
€
.
pro VE
302,00€
359,38€
inkl. Mwst. In denWarenkorb
Bei Artikel 6.261 361 bezieht sich der Preis von 302,00
€
auf die Verpackungseinheit 48.Der rechnerische Preis pro Stück ist 6,29
€
.
pro VE
302,00€
359,38€
inkl. Mwst. In denWarenkorb
Bei Artikel 7.644 322 bezieht sich der Preis von 302,00
€
auf die Verpackungseinheit 48.Der rechnerische Preis pro Stück ist 6,29
€
.
pro VE
308,00€
366,52€
inkl. Mwst. In denWarenkorb
Bei Artikel 7.628 681 bezieht sich der Preis von 308,00
€
auf die Verpackungseinheit 48.Der rechnerische Preis pro Stück ist 6,42
€
.
Beschreibungfür feste Medien
Menge
pro VE
120pro VE
1 VE478,40
€
EUR569,30€
EUR inkl. Mwst.Bitte wählenIn den
Warenkorb
Warenkorb
Beschreibungvorgefüllt mit Cetrimid-Agar
Menge
pro VE
48pro VE
1 VE426,40
€
EUR507,42€
EUR inkl. Mwst.Bitte wählenIn den
Warenkorb
Warenkorb
Beschreibungvorgefüllt mit Mac Conkey-Agar
Menge
pro VE
24pro VE
1 VE208,00
€
EUR247,52€
EUR inkl. Mwst.Bitte wählenIn den
Warenkorb
Warenkorb

Beschreibungvorgefüllt mit R2A-Agar
Menge
pro VE
48pro VE
1 VE302,00
€
EUR359,38€
EUR inkl. Mwst.Bitte wählenIn den
Warenkorb
Warenkorb
Beschreibungvorgefüllt mit Sabouraud-Dextrose-Agar mit Chloramphenicol
Menge
pro VE
48pro VE
1 VE392,60
€
EUR467,19€
EUR inkl. Mwst.Bitte wählenIn den
Warenkorb
Warenkorb

Beschreibungvorgefüllt mit Trypticase-Soja-Agar
Menge
pro VE
48pro VE
1 VE302,00
€
EUR359,38€
EUR inkl. Mwst.Bitte wählenIn den
Warenkorb
Warenkorb
Beschreibungvorgefüllt mit m-Endo-LES-Agar
Menge
pro VE
48pro VE
1 VE302,00
€
EUR359,38€
EUR inkl. Mwst.Bitte wählenIn den
Warenkorb
Warenkorb

Beschreibungvorgefüllt mit Plate-Count-Agar
Menge
pro VE
48pro VE
1 VE308,00
€
EUR366,52€
EUR inkl. Mwst.Bitte wählenIn den
Warenkorb
Warenkorb
